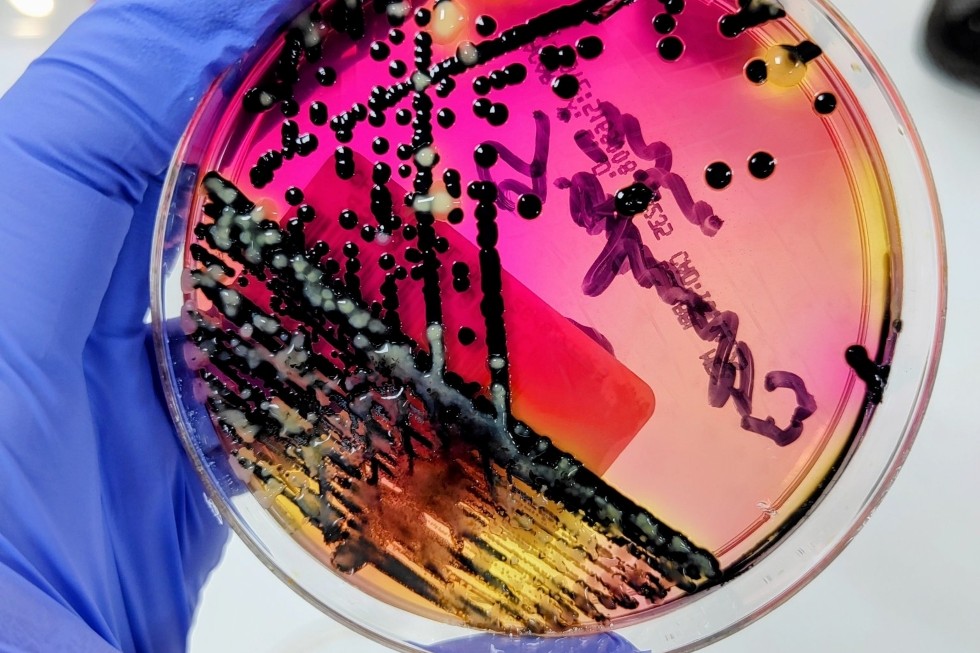

Sanidad ha confirmado un brote de salmonella en Gran Canaria que afecta a diecisiete personas, todas ellas pacientes del Hospital Universitario Insular y del Hospital Juan Carlos I. Nueve corresponden al primer centro y ocho al segundo, donde han presentado síntomas gastrointestinales asociados a la toxiinfección.
De los afectados, diez ya han superado la infección, tres recibieron el alta hospitalaria y otros siete obtuvieron el alta epidemiológica, aunque permanecen ingresados por patologías previas no relacionadas con la salmonella.
Tras detectarse los primeros casos, la Dirección General de Salud Pública y la Gerencia del Complejo Hospitalario Universitario Insular–Materno Infantil activaron de inmediato los protocolos de seguridad.
Entre las medidas aplicadas se encuentra la inmovilización de los alimentos sospechosos, que eran elaborados en la cocina del propio complejo y suministrados también al Hospital Juan Carlos I, para impedir nuevos contagios.
Las autoridades sanitarias han tomado muestras tanto de los pacientes como de los alimentos, cuyo análisis permitirá determinar el origen exacto del brote.

Normas de participación
Esta es la opinión de los lectores, no la de este medio.
Nos reservamos el derecho a eliminar los comentarios inapropiados.
La participación implica que ha leído y acepta las Normas de Participación y Política de Privacidad
Normas de Participación
Política de privacidad
Por seguridad guardamos tu IP
216.73.216.159